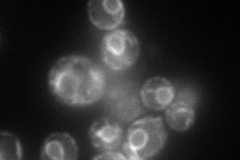
YOR085W
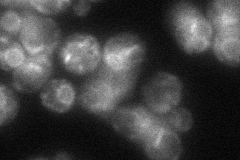
YOR085W
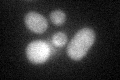
YOR085W

View description
Gamma subunit of the oligosaccharyltransferase complex of the ER lumen, which catalyzes asparagine-linked glycosylation of newly synthesized proteins; Ost3p is important for N-glycosylation of a subset of proteins
Localization:
Intensity:
Fold change:
Significance:
-
C’ GFP library in SD

ambiguous19.3 -
N' NOP1pr-GFP in SD
ER143.545 -
N' TEF2pr-mCherry in SD

ERN/A -
N' NATIVEpr-GFP in SD
ER45.0112 -
N' TEF2pr-VC and Cyto-VN in SD

#N/A0 -
C’ GFP library in SD+DTT
ambiguous18.110.93No -
C’ GFP library in SD+H2O2

ambiguous19.921.03No -
C’ GFP library in Starvation Media

ambiguous21.121.09No -
C’ GFP library on the background of Pup2-DaMP

N/A -
C’ GFP library on the background of CCT mutant

N/A0N/AYes
